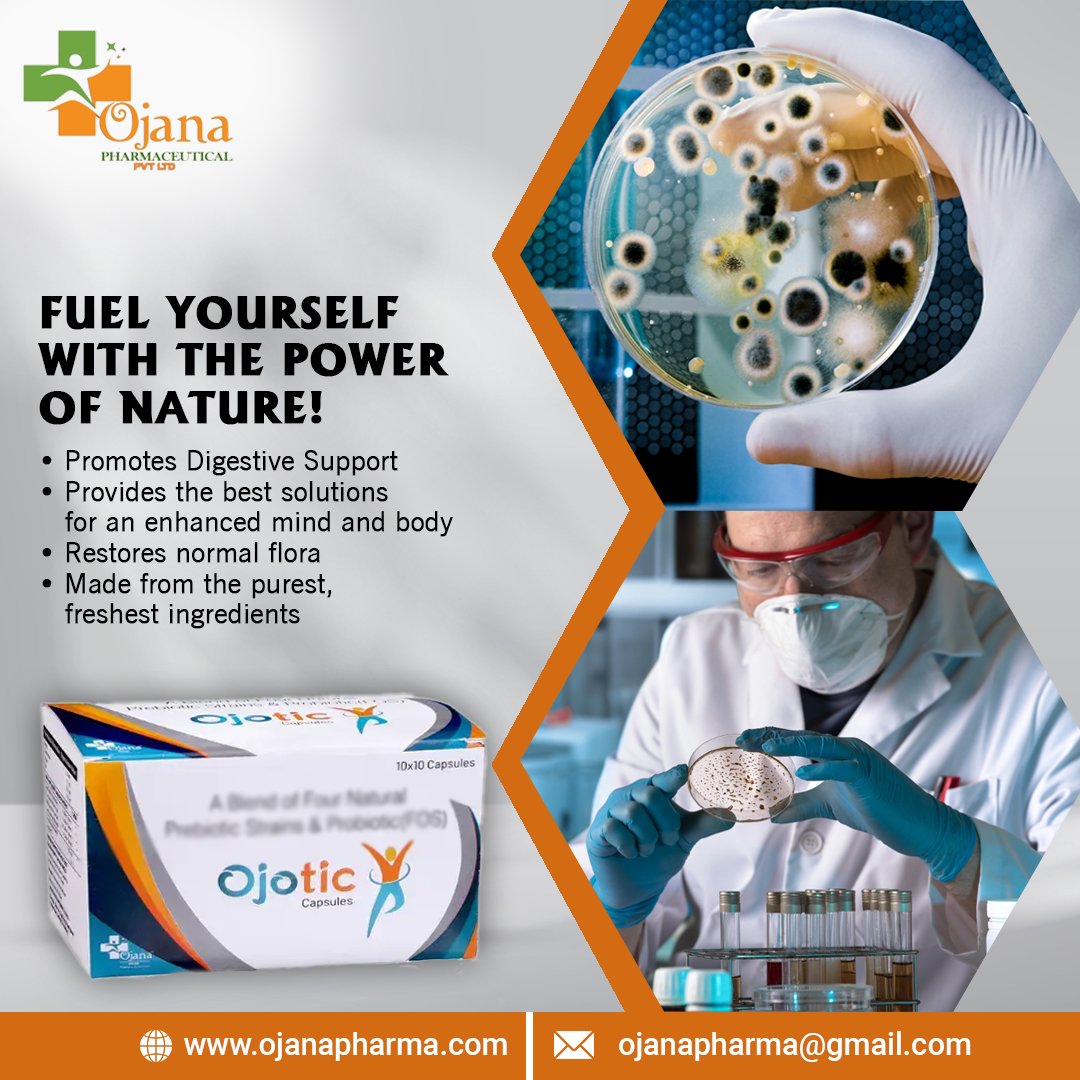
OjanaPharma's tweet image. 𝗢𝗷𝗼𝘁𝗶𝗰 𝗖𝗮𝗽𝘀𝘂𝗹𝗲𝘀💊:This medication is used to treat bowel problems such as diarrhea, irritable bowel, eczema &amp;amp; urinary tract infections.😇

Contact Us:
7206854542
#medication #bowelproblems #diarrhea #UTI #stayhealthy #healthcare #healthyliving #pharma #pharmacompany

#bowelproblems ผลการค้นหา
I need to buy myself a little stool for the restroom…I always lay down the toilet paper holder thingy because I need my legs to be raised so I can shit better #bowelproblems
can’t even say #trustyourgut cos my gut was having #bowelproblems
Bowel Problems? Curd Rice Might Be The Gut-Friendly Hero You Need food.ndtv.com/health/bowel-p… #curdrice #bowelproblems #guthealth

It's a problem we can all face... THE DAY I HELD MY FART IN xenoxnews.com/artist/poets-c… #Auspol2025 #auspolitics #BowelProblems
xenoxnews.com
THE DAY I HELD MY FART IN
Inspired by a quote. Mother told me to get out of bed, so i did. And glided out of my bedroom door with my belly a ballast of methane and my...
BREAKING NEWS!!! South Carolina OC Dowell Loggains will start going by “Bowel Loggains” because of how bad he shit the bed today! #bowelproblems #shitter
stop cause why do i spend half of my break in the bathroom #bowelproblems
The constant worry of being a Mum…getting quite anxious now about whether @alexmac06 will stay well for our hols that are coming up ….. He’s not been 100% today & the worry’s kicking in 🫨 #FeelingStressed #BowelProblems Just wish I knew why he keeps having the same problem🤔🤦🏻♀️
I just want to eat cassava, mangoes, African plums, alligator, mouton and all the tropical fruits I was raised on. My body is literally rejecting Western, over processed diets. #IBS #IBSD #bowelproblems #dietaryissues #allergies
I'm just a baby... I could use a big nappy, especially when I get the shits! #ibs #bowelproblems #comedyvideos #funnyvideos #viralvideo
October is #SpinaBifidaAwarenessMonth! Quint lives with #SpinaBifida and #BowelProblems. Peristeen® Plus provided him a long-term solution without having to worry about accidents! Learn more: bit.ly/3wmeQ9x

This week we are helping to raise awareness of #BowelProblems and #UrinaryIncontinence. We understand how important it is to find the right #incontinence products to fit your life. Our Care Advisors are here to help support you in finding the perfect product solutions!

#WorldContinenceWeek is regarding #bladder and #bowelproblems, #pelvicpain, and other conditions that impact patients know more :bit.ly/3qS9PGs #continenceawareness #WCW #continenceprevention #continencetreatment #pelvichealth #pelvicproblems #painmanagement

Do you experience #BowelIssues? This week is #WorldContinenceWeek and we're helping to raise awareness of #BowelProblems and #MS. Bowel issues are common symptoms in #MultipleSclerosis. Click the link below for information and support. pulse.ly/uy5t8pfiss #MSAwareness
mstrust.org.uk
Bowel problems
Bowel problems in multiple sclerosis can include constipation, bowel accidents and loose bowel movements. Treatment options include medication, transanal irrigation, pelvic floor exercises, biofeed...
Happy 4th stomaversary Apple 🍎 apple has decided to be naughty today and not have any output since school yesterday #bowelproblems #chroniccondition #stomaversary


Bowel Problems? Curd Rice Might Be The Gut-Friendly Hero You Need food.ndtv.com/health/bowel-p… #curdrice #bowelproblems #guthealth

Everything I've had in the last 24hours has left my system. My bowels hate me. And I hate them. 😭😭😭 #bowelproblems #coeliac #ibs
Thank you @BladderAndBowel for my #CantWaitCard. Very useful and free, here is the link... bladderandbowel.org/help-informati… #bladderproblems #bowelproblems #makinglifeeasier

𝗢𝗷𝗼𝘁𝗶𝗰 𝗖𝗮𝗽𝘀𝘂𝗹𝗲𝘀💊:This medication is used to treat bowel problems such as diarrhea, irritable bowel, eczema & urinary tract infections.😇 Contact Us: 7206854542 #medication #bowelproblems #diarrhea #UTI #stayhealthy #healthcare #healthyliving #pharma #pharmacompany
April is #IBSAwarenessMonth. #IrritableBowelSyndrome is a disorder in which a person experiences abdominal pain and recurrent #BowelProblems, such as #Constipation and diarrhea. “Don’t suffer in silence”, talk to our #Pharmacist to see how we can help you minimize symptoms. #IBS

April is #IBSAwarenessMonth. #IrritableBowelSyndrome is a disorder in which a person experiences abdominal pain and recurrent #BowelProblems, such as #Constipation and diarrhea. “Don’t suffer in silence”, talk to our #Pharmacist to see how we can help you minimize symptoms. #IBS

April is #IBSAwarenessMonth. #IrritableBowelSyndrome is a disorder in which a person experiences abdominal pain and recurrent #BowelProblems, such as #Constipation and diarrhea. “Don’t suffer in silence”, talk to our #Pharmacist to see how we can help you minimize symptoms. #IBS

This week we are helping to raise awareness of #BowelProblems and #UrinaryIncontinence. We understand how important it is to find the right #incontinence products to fit your life. Our Care Advisors are here to help support you in finding the perfect product solutions!

All evening Jessica has been getting upset and feeling down for no known reason this isn't like Jessica, apple has been playing up for a while so not sure if that's what's effecting her moods but she wants mummy cuddles #anxiety #moodchanges #bowelproblems #brave #anxious
When you were with your narc, did you: suffer with #bowelproblems? suffer with #anxieties? Did you know that the two are connected deeply? Prolong anxieties, #trauma and #fear will continue to cause even more health issues connected to the bowels.

April is #IBSAwarenessMonth. #IrritableBowelSyndrome is a disorder in which a person experiences abdominal pain and recurrent #BowelProblems, such as #Constipation and diarrhea. “Don’t suffer in silence”, talk to our #Pharmacist to see how we can help you minimize symptoms. #IBS

Squatting, a healthier way of eliminating your stools, much better that sitting. Try #squateasy today and squat forever. #bowelproblems #haemoroids #pelvicfloor #healthy #toilet #feelgood #squatting

April is #IBSAwarenessMonth. #IrritableBowelSyndrome is a disorder in which a person experiences abdominal pain and recurrent #BowelProblems, such as #Constipation and diarrhea. “Don’t suffer in silence”, talk to our #Pharmacist to see how we can help you minimize symptoms. #IBS

April is #IBSAwarenessMonth. #IrritableBowelSyndrome is a disorder in which a person experiences abdominal pain and recurrent #BowelProblems, such as #Constipation and diarrhea. “Don’t suffer in silence”, talk to our #Pharmacist to see how we can help you minimize symptoms. #IBS

#IBS is a condition characterized by chronic #AbdominalDiscomfort & #BowelProblems. If not treated appropriately, it can seriously affect a person’s physical and mental well being. #April is #IrritableBowelSyndrome awareness month, to raise awareness about this condition.

April is #IBSAwarenessMonth. #IrritableBowelSyndrome is a disorder in which a person experiences abdominal pain and recurrent #BowelProblems, such as #Constipation and diarrhea. “Don’t suffer in silence”, talk to our #Pharmacist to see how we can help you minimize symptoms. #IBS

Something went wrong.
Something went wrong.
United States Trends
- 1. #ALLOCATION 200K posts
- 2. The BIGGЕST 440K posts
- 3. #JUPITER 199K posts
- 4. #GMMTVxTPDA2025 481K posts
- 5. Good Tuesday 26.6K posts
- 6. #GivingTuesday 8,454 posts
- 7. Kanata 23K posts
- 8. #AreYouSure2 47.7K posts
- 9. JOSSGAWIN AT TPDA2025 69K posts
- 10. JIMMYSEA TPDA AWARD 2025 53.6K posts
- 11. SNOW DAY 7,337 posts
- 12. Lakers 49K posts
- 13. Dart 38.4K posts
- 14. Costco 28.3K posts
- 15. Hololive 15.8K posts
- 16. Bron 26.3K posts
- 17. Dillon Brooks 8,023 posts
- 18. Penny 22.7K posts
- 19. STEAK 10.8K posts
- 20. Pentagon 54.7K posts




































